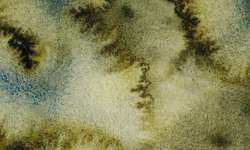
Metamorphoses Forest Brume

WHITE NIGHTS™ granulierende Künstler-Aquarellfarben, einzeln
Bitte wählen Sie eine oder mehrere Farben aus:
Klicken Sie auf die Farbe, um mehr zu sehen:

Zeichenerklärung
Die WHITE NIGHTS™ granulierende Künstler-Aquarellfarben ermöglichen ganz neue Techniken in der Aquarellmalerei. Während die Farbe trocknet, sammeln sich Pigmentteilchen in unterschiedlicher Stärke an und sorgen für eine veränderte Oberflächenstruktur mit einer körnigen Optik und einzigartigen Schattierungen. Je nach Stärke des Farbaufstrichs und Art der Pinselstriche lassen sich ganz unterschiedliche Effekte erzielen.
Extrafeine russische Künstler-Aquarellfarbe aus der traditionsreichen St. Petersburger Künstlerfarben-Manufaktur: Die Farben sind hervorragend pigmentiert und von hoher Brillanz und Leuchtkraft. Diese feuchte Aquarellfarbe enthält Bindemittel aus natürlicher Herkunft, unter anderem Gummiarabicum und Honig, und wird noch im traditionellen Verfahren flüssig in mehreren Arbeitsgängen in die Näpfchen verfüllt. Sie ist farbstark und hoch lichtbeständig, eignet sich hervorragend für alle Aquarelltechniken und wird aufgrund ihres außergewöhnlichen Preis-Leistungs-Verhältnisses von Aquarellisten in der ganzen Welt verwendet.
WHITE NIGHTS™ granulierende Künstler-Aquarellfarben auf einen Blick:
- Alle Farbtöne mit höchster Lichtechtheit
- Halbtransparente Farben
- Für granulierende Aquarelltechniken
- Hochpigmentiert
- Erhältlich in ganzen Näpfchen und in der 10-ml-Tube
Nevskaya Palitra Artistic paints
68, Serdobolskaya ul. 68
197342 St. Petersburg
RU
secretarfsdf@zxknp.spb.ru



























